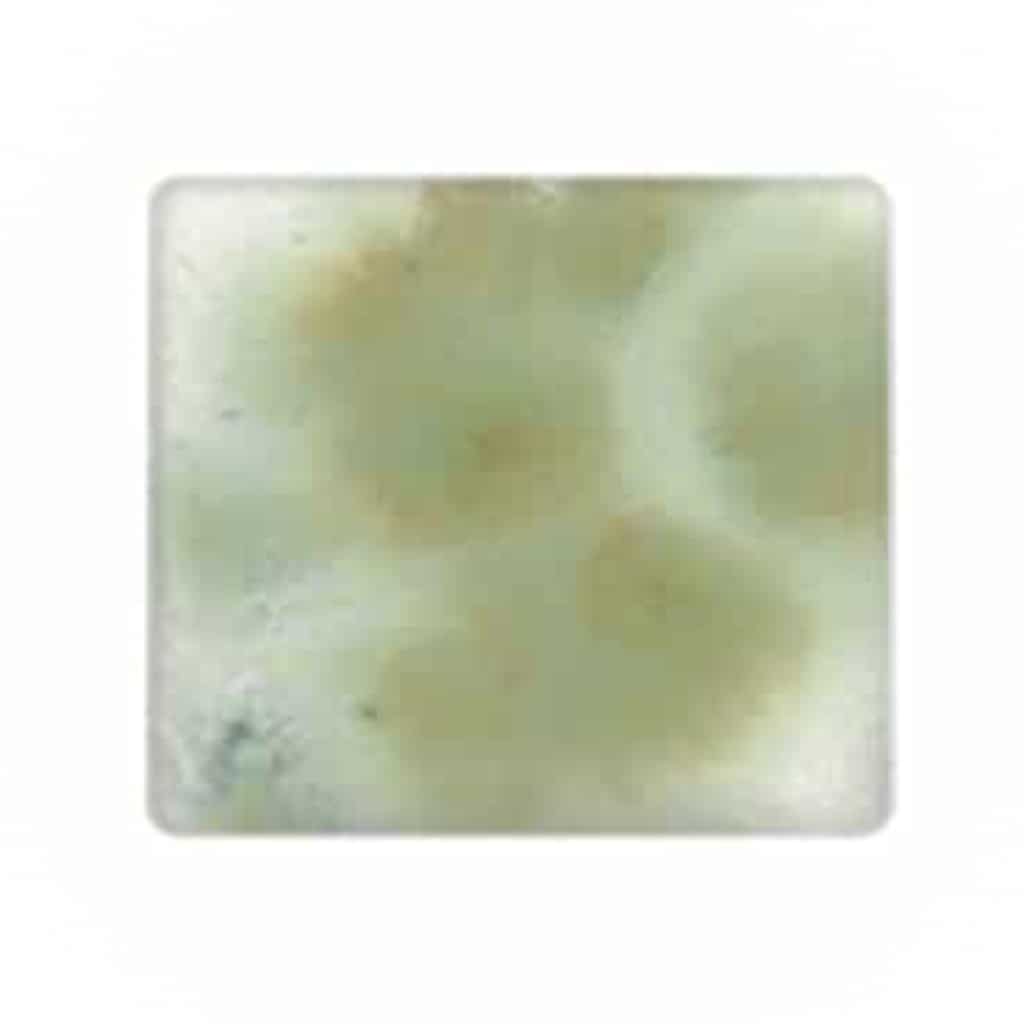

Spectrum Glaze Crystals – CR-09 Reactive Green – 1 oz
$10.00
Cone 06 to Cone 6. Spectrum Glaze Crystals are all lead-free and dinnerware safe when fired to a minimum cone 06.
Free US Shipping on this product when you order $50 or more of qualifying items. Terms apply. Learn More
Details
- size: 1 oz.
- finish: Speckled
- glaze type: Glaze
- glaze color: Green
Glaze Overview
Spectrum Glaze Crystals are all lead-free and dinnerware safe when fired to a minimum cone 06. These crystals are very versatile and can be used successfully from cone 06 to cone 6.
Shop Pottery Glazes
Put the finishing touches on your ceramic creations! Clay-King has a massive selection of glazes for all types of potters – from classrooms to home hobbyists. We make it easy to sort and shop by brand, color, type, finish, and more. Our shop carries all your favorite brands to make finding the right glaze for a project easier than ever.
Glaze is a glassy melted coating that is fired onto ceramic pieces. Once fired, glazes may be glossy, satin, or matte. If you’re creating clay surfaces intended to hold food, a gloss glaze is an excellent option because it makes it easier to clean the dish. A matte glaze will be non-reflective and can be smooth or stony to the touch. Satin glazes will have a low, waxy sheen that is smooth in texture.
Underglazes are commercial products made up of finely ground clays and frits with oxides and stains. Underglazes usually require a clear or transparent glaze on top of them to seal the surface. You can paint, pour, spray, or dip the underglazes on your creations. Usually, underglazes require three coats. However, Clay-King offers one-coat products that are often fluxed to produce a low sheen.
No matter your pottery glaze needs, Clay-King can help!
Why Choose Clay-King for Pottery Glazes?
When you shop with Clay-King, you’re choosing a company that stands behind our products. Whether it’s pottery glazes or a pottery kiln, you can rely on our team to provide unbeatable customer service and help you succeed.
Massive Pottery Glazes Inventory
Clay-King is a leading supplier of pottery glazes and ceramic pottery products. Our warehouse is always stocked with pottery glazes from the top brands and in a variety of colors. Plus, you can easily find pottery tools, bisqueware, and accessories you’ll need for your project.
Fast Shipping on Pottery Glazes
Thanks to our in-house warehouse department, we can ship your pottery glazes fast! You can expect speedy delivery and expert packing so your pottery glazes arrive in the best condition possible.
Incredible Customer Service
Our experienced potters and customer service team supports you every step of the way. Whether it’s a question about the best technique to glaze your clay creation or you’re seeking recommendations for your next project, our experts are here to help!